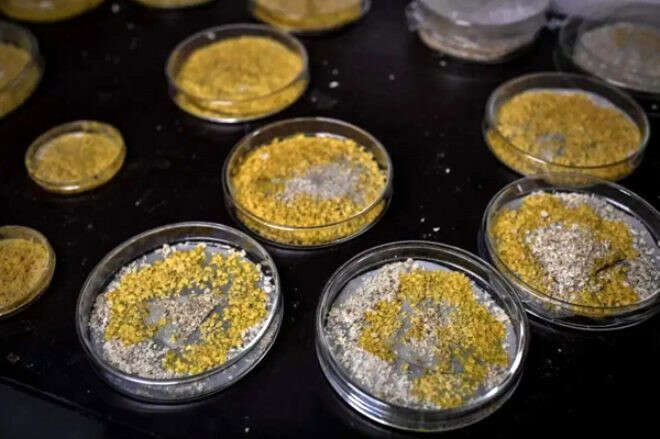

Ürküten keşif! 720 cinsel organı var, ama beyni yok!
Bilim insanları şokta. Yosunu andıran bu tek hücreli canlı mantar gibi görünüyor ama bir hayvan gibi hareket ediyor ve tam 720 cinsel organa sahip. Ne olduğu tam olarak çözülemeyen bu canlıya 'Blob' adı verildi. İşte 2 dakikada kendini iyileştirebilen dünyanın en ilginç canlısı.
Oluşturulma Tarihi: 3 Haziran 2020, Çarşamba 09:06
Paris Hayvanat Bahçesi'nde sergilenen ilk bitki olan Blom yani 'Damla' tek hücreli ve doğanın gizemlerinden biri olarak görülüyor. Hayvanat bahçesinin bu tuhaf misafiri 'beyni' olmamasına rağmen 'öğrenme yeteneği' ile büyülüyor. Dahası kendini 2 dakikada iyileştirebiliyor.
Blob (damla) isimli sarı yosuna benzeyen bu organizma, mantar gibi görünüyor ama bir hayvandan farkı yok!
Bilim adamları bitki görünmesine rağmen bunun 'bitki olmadığından' kesinlikle eminler ve onu "Mantarla hayvan arası bir şey" diye tanımlıyorlar.
Beyni, ağzı ve gözleri yok. 720 cinsiyeti var. Paris Ulusal Doğa Tarihi Müzesi Bruno David bitkiyle ilgili esrarengiz bilgileri şöyle aktardı:
İki Blob'u birleştirildiğinde biri bilgisini hemen diğerine aktarıyor. Böylece diğeri anında 'tuz' bariyerini nasıl geçeceğini biliyor. Doğada merak edilen pek çok canlı var ama onlar arasında hayvanat bahçesinde yerini alan ilk canlı o oldu.
Blob'un bacakları da yok fakat bu durum saatte 4 cm mesafe kat etmesine engel değil.
Uzman David, Blob'un diğer özelliklerini şöyle sıralıyor:
SON GALERİLER
-

-

-

-

-

-

-

-

-

-